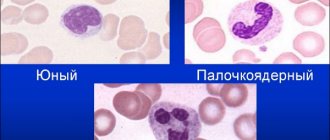

Виды
В медицине существуют различные классификации коронарно-легочных свищей, но в большинстве случаев у пациентов диагностируют следующие виды:
| Название | Описание |
| Врожденная фистула | Патологическое состояние диагностируется в 98-99% случаев у пациентов с другими сердечными пороками. |
| Приобретенная | Основная причина – это хирургическое вмешательство в области сердечной мышцы или коронарных сосудов. |
У пациентов в 50% случаев диагностируют правостороннюю коронарно-легочную фистулу. В 30% случаев происходит поражение левой коронарной артерии. В 4% случаев – это двусторонний свищ, а 7% — это единичный патологический свищ.
Степень тяжести заболевания также зависит от типа дренирования фистулы. Учитывая эти данные, коронарно-легочный свищ предусматривает следующую классификацию:
| Название | Описание |
| Артериовенозные соустья | Коронарная патология диагностируется у пациентов в 90% случаев. Врожденная аномалия, которая возникает в результате сообщения коронарной артерии и правого отдела сердца, коронарного синуса или легочного ствола. |
| Артерио-артериальная фистула | Патологическое состояние диагностируется в 10% случаев. Выходное отверстие находится между кровеносными сосудами, которые питают ткани миокарда и левым предсердием либо желудочком. |
Каждый вид или форма заболевания сопровождается характерными клиническими признаками, которые помогут врачу кардиологу поставить точный диагноз. Существуют также одиночные или множественные сосудистые патологии. Маленькие свищи не превышают размеры в диаметре 2 мм. У больших фистул формируются шунты, размером больше 2 мм.
Российское научное общество специалистов по рентгенэндоваскулярной диагностике и лечению
Горбатых А.В., Крестьянинов О.В., Сойнов И.А., Ничай Н.Р,Войтов А.В., Иванцов С.М.ФГБУ «ННИИПК им. акад. Е.Н. Мешалкина» Минздрава России
Абстракт
Коронарно-сердечные фистулы – редкий врожденный порок коронарной циркуляции. Как правило, течение порока благоприятное, однако при большой коронаро-правопредсердной фистуле возникает объемная перегрузка с прогрессирующей сердечной недостаточностью. Традиционно принято закрывать такие фистулы с помощью искусственного кровообращения. Мы представляем случай эндоваскулярного закрытия большой коронаро-правопредсердной фистулы.
Ключевые слова: Коронарно-сердечная фистула; врожденный порок сердца; транскатетерная эмболизация; аномалия коронарных сосудов
Введение
Коронарно-сердечные фистулы – редкий врожденный порок коронарной циркуляции. Течение коронарно-сердечной фистулы в большинстве случаев бессимптомное, а постановка диагноза, как правило, является диагностической находкой при выполнении ЭХО КГ, ангиографии, МРТ или КТ сердца [1]. Однако развитие частых осложнений синдрома «обкрадывания» коронарного кровотока, тромбоза и эмболия коронарного русла, прогрессирующей сердечной недостаточности, фибрилляция предсердий требует раннего оперативного вмешательства [2]. В настоящее время данная патология устраняется с помощью искусственного кровообращения [3]. Мы представляем успешный клинический случай эндоваскулярного закрытия коронаро-правопредсердной фистулы. Клинический случай
Мальчик Е. 11 лет 29 кг, поступил в клинику с диагнозом коронарно-предсердная фистула с жалобы на одышку при физической нагрузке, быструю утомляемость. По данным рентгенографии грудной клетки СЛК 65%. Трансторакальное ЭХО КГ показало расширение устья и ствола левой коронарной артерии до 1 см, а также турбулентный поток в правом предсердии, по цветной доплерографии размер потока 4,8 мм, повышено расчетное давление в ЛА 48 торр. На МСКТ исследовании с контрастом, подтверждена коронаро-правопредсердная фистула. Диффузно расширенный сосуд 10,5х8,5 мм, отходил от левого синуса Вальсальвы, который имел U-образный изгиб от которого отходили Cx и LAD. Ретроаортально между восходящей аортой и левым предсердием расширенный сосуд дренировался в полость правого предсердия в виде двух теснорасположенных стволов диаметрами 7 мм и 6 мм.
Для дальнейшего исследования пациент направлен на катетеризацию сердца. Исследование выполнено на спонтанном дыхании, без кислорода. Сосудистый доступ осуществлялся через правую бедренную вену и левую бедренную артерию. Использовались диагностические катетеры 4 Fr Terumo. Контрастирована коронаро-правопредсердная фистула, выявлено максимальное расширение до 13 мм. При выполнении селективной коронарографии стенозирующей патологии коронарных артерий не выявлено. Определяется нормальная анатомия венозного возврата в истинный корорнарный синус, который расположен в правом предсердии. Давление в ПП 14/8(11) торр, в ПЖ 50/3(23) торр. Произведены заборы крови из камер сердца и магистральных сосудов на оксигинацию — Qp/Qs 1.6. (рис. 1).
Рис. 1: МСКТ коронаро-правопредсердной фистулы: А) трехмерная реконструкция КФ, краниальная проекция; B) контрастное МСКТ, прямая проекция, отношение фистулы и ЛКА; С) прямая проекция, показано место дренирования КФ двумя раздельными стволами в правое предсердие.
Через артериальным доступом проведен проводник Wishper 0.014″ через фистулу в правое предсердие и НПВ, выполнен захват проводника ловушкой типа «лаcсо», проводник выведен через венозный доступ, таким образом сформирована артериовенозная петля. Венозным доступом по коронарному проводнику проведено доставочное устройство SFP8 Fr, по которому в фистулу доставлен PDA окклюдер «LifeTech» XJFD 1012.Окклюдер расположен в полости фистулы, проксимальнее деления фистулы на стволы, таким образом закрыт весь просвет фистулы. Контрольная ангиография показала минимальный сброс контраста через тело окклюдера. Давление в ПЖ 30/4 торр. Осложнений во время процедуры не было. Время операции 35 мин, рентгеноскопии 12 мин. (рис. 2).
Рис. 2: А) Сформирована «артериовенозная петля» для проведения системы доставки чрезвенозным доступом; B) доставочное устройство установлено в КФ; С) контрольная ангиография, PDA окклюдер полностью закрывает полость КФ.
На места сосудистых доступов наложены давящие повязки, после процедуры ребенок был доставлен в общее отделение, повязки были удалены через 12 часов. Аускультативно не определяется диастолического шума, а также по данным ЭХО КГ патологического сброса в ПП не выявлено, фистула закрыта герметично. Через 4 суток ребенок был выписан в удовлетворительном состоянии.
Через 6 месяцев после операции выполнено контрольное ЭХОКГ по данным которого: сбросов на уровне фистулы нет.
Дискуссия
Коронаро-правопредсердная фистула редкая врожденная патология, частота которой составляет 0,08-0,1% от всех врожденных пороков сердца. Первое описание этого порока сделала Krause 1865г. Первое успешное хирургическое лечение выполнили в 1947 г Bjork и Crafoord. Естественное течение порока, как правило, благоприятное, однако при большой коронаро-правопредсердной фистуле возникает объемная перегрузка с прогрессирующей сердечной недостаточности и легочной гипертензии. Поэтому отношение Qp/Qs более 1.5, как и при любых септальных дефектах, является абсолютным показанием к хирургическому лечению [4,5]. У пациента, описанного в нашем клиническом случае, имелись все признаки объемной перегрузки правых отделов сердца (СЛК 65%, давление в ПЖ 50/3(23) торр), отношение Qp/Qs составило 1,6, это и явилось для нас показанием к оперативному лечению. В настоящее время предложено множество способов закрытия коронарных фистул, от традиционного метода операции на открытом сердце в условиях ИК, до эмболизации клеевыми растворами небольших коронарных фистул [6]. Для определения выбора метода хирургической коррекции, мы провели МСКТ исследование и коронарографию. МСКТ исследование показало пространственное расположение коронарной фистулы с правым предсердием, а коронарография анатомию коронарного русла. Учитывая все преимущества эндоваскулярного лечения над операциями под ИК, мы выполнили эмболизацию коронаро-правопредсердной фистулы окклюдером PDA c хорошим клиническим и ангиографическим результатом. Проведя контрольное ЭХОКГ исследование через 6 месяцев, мы не обнаружили резидуальных шунтов.
Заключение
Наш клинический случай показывает, что при подходящей анатомии коронаро-правопредсердной фистулы эндоваскулярная эмболизация возможна и является безопасной процедурой.
- Wanes C.A., Williams R.G., Bashore T.M. et al. ACC/AHA 2008 Guidelines for the Management of adult with Congenital Heart Disease: report of the American College of Cardiology/American Heart Association Task Forse on Practice Guidelines (writing committee to develop guidelines on the management of adult with congenital heart disease). Circulation. 2008; 118 (23): 714–833.
- Chirantan V. Mangukia. Coronary artery fistula. Ann. Thorac. Surg. 2012; 93: 2084–92.
- Yorihiko Matsumoto, Takaya Hoashi, Koji Kagisaki, and Hajime Ichikawa. Successful surgical treatment of a gigantic congenital coronary artery fistula immediately after birth. Interact Cardiovasc Thorac Surg. 2012 Sep; 15(3): 520–522.
- Wang NK, Hsieh LY, Shen CT, Lin YM. Coronary arteriovenous fistula in pediatric patients: a 17-year institutional experience. J Formos Med Assoc 2002;101:177-82.
- Омельченко А.Ю., Ничай Н.Р., Горбатых Ю.Н. Миниинвазивные технологии закрытия дефектов межжелудочковой перегородки. // Патология кровообращения и кардиохирургия. 2015. № 1. С. 110–118.
- Karagoz T, Celiker A, Cil B, Cekirge S. Transcatheter embolization of a coronary fistula originating from the left anterior descending artery by using n-butyl 2-cyanoacrylate. CardiovascInterventRadiol 2004; 27: 663-5.
Этиология и распространенность
У всех пациентов с врожденным пороком сердца (ВПС) в 0,2-0,4% случаев диагностируется коронарно-легочная фистула. Из них 0,08-0,18% — это взрослые люди. Фистула может появиться без сопутствующих клинических признаков. Определить ее помогает физикальное обследование.
Невозможно установить распространенность коронарных фистул, поскольку маленькие свищи редко диагностируются в ходе профилактического обследования или при лечении другого заболевания. Патологические свищи маленького размера протекают тихо, не нарушая миокардиального кровообращения.
В такой ситуации симптомы сердечной дисфункции отсутствуют. Иногда маленькая фистула спонтанно закрывается, а в некоторых ситуациях продолжается расти и провоцирует возникновение характерных клинических признаков.
Патологический свищ большого размера прогрессирует и вызывает серьезные осложнения (инфаркта миокарда, аритмию, застойную сердечную недостаточность, разрыв кровеносных сосудов, аневризму и даже смерть человека).
СБУГ — Аномальное отхождение коронарной артерии от легочной артерии
В современной кардиологии за названиями пороков часто закрепляется сокращенное название — аббревиатура (а за названиями операций — фамилии врачей, впервые предложивших методику, например, операция Фонтена). Обычно эти аббревиатуры образуются от слов в названии порока — ДМЖП (дефект межжелудочковой перегородки), ОАП (открытый артериальный проток) и др. Краткое название порока «аномальное отхождение коронарной артерии от легочной артерии» образовано по другому принципу: от первых букв имен врачей, которые впервые описали этот порок – Блант, Уайт, Гарланд, а буква «С» вначале аббревиатуры означает «синдром».
В правильно развитом сердце обе коронарные, или венечные, артерии, которые несут артериальную кровь для самого сердца, отходят от начала восходящей аорты, у самого ее корня. Это ее первые, важнейшие ветви, благодаря которым сердце получает свой кислород и питательные вещества.
При пороке сердца СБУГ, который мы сейчас рассматриваем, одна из коронарных артерий начинается не от аорты, а от рядом лежащей легочной артерии, в которой содержится венозная, а не артериальная кровь. Чаще всего это происходит с левой, т.е. главной артерией, которая питает большую часть сердечной мышцы.
Что же при этом происходит?
Во внутриутробной жизни обе коронарных артерии получают кровь под одинаковым давлением, т.к. в легочной артерии давление почти равно давлению в большом круге, а разница в насыщении крови кислородом незначительна.
Но после рождения условия кровотока в сердце резко меняются. По правой артерии продолжается поступление артериальной крови из аорты. А левая, а вместе с ней и вся масса мышц левого желудочка, получает артериальную кровь только через мелкие обходные пути, так называемые «коллатерали», из системы той же правой артерии. Из левой артерии часть крови вытекает в легочную артерию, не успев попасть в сосудистую сеть и отдать содержащийся в ней кислород. Происходит то, что называется «синдромом воровства». Для мышцы сердца такое воровство опасно: левые отделы начинают очень быстро страдать от недостатка кислорода и питательных веществ, а вся картина чрезвычайно напоминает и, в сущности, является ишемической коронарной болезнью
, столь хорошо известной всем. У СБУГ и у ишемии, которая часто развивается у людей пожилого возраста, совершенно разные причины. Однако, следствия очень похожи: сердечная недостаточность, инфаркты сердечной мышцы, сопровождающиеся сильнейшими болями, о которых грудной ребенок не может ничего сказать.
Симптоматика чаще всего проявляется в течение первых 4-х месяцев, а если ничего не будет предпринято, то до своего первого дня рождения не доживут почти 90% детей с этим пороком. У части детей коллатерали развиваются хорошо и дети могут перенести период новорожденности, но, тем не менее, требуют хирургической помощи.
В любом случае, как и при многих других пороках, диагноз должен быть известен как можно раньше. Обычно подозрение, а иногда и абсолютно правильный диагноз виден на обычной электрокардиограмме, картина которой при этом пороке достаточно типична.
Катетеризация сердца позволит точно определить место расположения устья левой коронарной артерии.
Методов хирургической коррекции несколько. Прежде всего, можно просто перевязать устье аномальной левой коронарной артерии. Это прекратит утечку, повысит давление в коронарном бассейне и значительно улучшит питание сердечной мышцы. Сегодня закрытие устья может быть сделано без операции, в рентгенохирургическом кабинете. Но, даже если это невозможно, то операция перевязки достаточно проста, не требует искусственного кровообращения и может быть выполнена в любой детской кардиохирургической клинике.
В ряде случаев можно наложить анастомоз между подключичной и коронарной артерией, перевязав ее устье. Это тоже закрытая операция. Обе они — паллиативны, т.е. не решают главной задачи: восстановление нормальной двукоронарной системы снабжения сердца кровью.
Понятно, что это можно решить только с помощью «пересадки» устья левой веночной артерии от легочной в аорту, туда, откуда она должна отходить. Для этого предложено несколько вариантов операций, и детали вам должен объяснить оперирующий вашего ребенка хирург.
Операция непростая, довольно длительная, выполняется в условиях искусственного кровообращения, и, что самое важное — не частая, т.к. этот порок встречается достаточно редко. Поэтому значительным опытом обладают только крупные центры, имеющие постоянный поток больных с врожденными пороками сердца.
Как попасть на лечение в Научный центр им. А.Н. Бакулева?
Онлайн-консультации
Стадии и степени
Клинические проявления коронарно-легочной фистулы помогут определить степень развития шунта, его расположение и размеры. Учитывая распространенность патологического состояния, различают следующие формы коронарно-легочной фистулы:
| Название | Описание |
| Генерализованная | Редкое патологическое состояние, которое характеризуется образованием множественных фистул с серьезным нарушением кровообращения. |
| Локализованная | Образуется один патологический шунт, который расположен между веной и артерией. В большинстве случаев появляется с другими сердечными пороками. |
В каждом случае у пациента появляются характерные клинические симптомы. Метод лечения врач кардиолог подбирает, учитывая поставленный диагноз и существующие патологические изменения.
Причины возникновения артериовенозных фистул
Артериовенозная фистула может возникнуть как осложнение такой процедуры как катетеризация полостей сердца. Во время катетеризации длинная тонкая трубка, называющаяся катетером, вводится в артерию или вену паховой области, шеи или руки и проводится через кровеносные сосуды к сердцу. Если игла, использованная для катетеризации, пересекает артерию и вену, создаются предпосылки для образования артериовенозной фистулы, но такое осложнение возникает не часто.
Травмы.
Так же возможно образование артериовенозной фистулы после огнестрельного или ножевого ранения. Это происходит при ранениях в той части тела, где вена и артерия плотно прилегают друг к другу.
Врожденные артериовенозные фистулы.
Некоторые люди имеют артериовенозные фистулы с рождения. Хотя причина возникновения врожденных артериовенозных фистул до конца не ясна, предполагается, что происходит нарушение развития артерий и вен во внутриутробном периоде.
Генетические заболевания.
Артериовенозные фистулы в легких могут быть вызваны наследственными заболеваниями (болезнь Рандю-Ослера-Вебера) в результате которых кровеносные сосуды развиваются патологически по всему телу, особенно в легких.
Хирургически созданная артериовенозная фистула.
Пациентам с терминальной стадией почечной недостаточности, для облегчения проведения диализа может быть создана хирургическим путем артериовенозная фистула. Если иглу для диализа вводят слишком много раз в вену, то она может зарубцеваться и перестать функционировать. Создание артериовенозной фистулы приводит к расширению вены, с помощью соединения с близлежащей артерией, что упрощает пункцию (прокалывание) и позволяет создать более высокую скорость кровотока. Обычно АВ фистулу формируют на предплечье.
Симптомы
Клиническая картина патологического состояния зависит от размеров образовавшегося свища. В случае появления небольшого отверстия признаки коронарно-легочной фистулы отсутствуют.
Ярко выраженная клиническая картина проявляется при значительной перегрузке одного из желудочков, на фоне чего часто возникает сердечная недостаточность. Ребенка в возрасте 2-3 месяца госпитализируют с нарушениями в работе сердечно-сосудистой системы.
У детей коронарно-легочная фистула характеризуется следующими симптомами:
- бледнеют кожные покровы;
- ребенок быстро устает во время кормления, поэтому часто отказывается от груди;
- появляется нервная возбудимость;
- малыш медленно набирает вес;
- во время крика у ребенка синеет носогубный треугольник;
- повышается потоотделение;
- учащается дыхание;
- возникает тахикардия, стенокардия;
- наблюдается замедление физического развития.
Прогрессирующие патологические процессы провоцируют симптомы сердечной недостаточности. В некоторых ситуациях у пациентов отекают ноги, увеличивается печень, появляется сильная отдышка и кашель. В ночное время нарушается дыхательный процесс, слышен хрип.
У взрослых пациентов приобретенная коронарно-легочная фистула характеризуется следующими клиническими симптомами:
- сердечная недостаточность прогрессирует;
- появляется сильная отдышка;
- учащается сердечный ритм;
- снижается работоспособность;
- увеличивается печень;
- появляется общая слабость в теле;
- пациенты жалуются на отеки нижних конечностей, особенно в вечернее время;
- в некоторых ситуациях появляется болевой синдром за грудиной, который отдает в левую лопатку, руку.
У молодых людей появляется пароксизмальная мерцательная аритмия, которая сопровождается сбоями в работе сердца, отдышкой и грудными болезненными ощущениями.
Значительная перегрузка сердечных отделов приводит к тому, что появляются выраженные симптомы хронического нарушения кровообращения. В конечном результате это чревато развитием острой сердечной недостаточности.
Многие проявления коронарно-легочных свищей возникают во время физической нагрузки. Болевой синдром появляется в области грудной клетки, по ощущениям напоминает приступ стенокардии, сопровождается обмороками. В редких случаях у пациентов диагностируют эндокардит.
Нельзя игнорировать симптомы заболевания, поскольку ярко выраженная картина указывает на присутствие коронарно-легочной фистулы среднего и большого размера. Без своевременной терапии повышается риск возникновения инфаркта.
Cиндром Бланда-Уайта-Гарланда
Аномалии коронарных артерий — почти terra incognita для современной кардиологии, в то же время, по разным данным, они обнаруживаются у 0,6 % – 5,64 % кардиологических пациентов, однако есть вероятность, что частота встречаемости намного выше. Недостаточно изучены анатомические варианты коронарных сосудов, их патофизиологическое и клиническое значение, прогноз, вследствие чего нет обоснованных рекомендаций по лечению пациентов, часты ошибки в диагностике и выборе лечения.
В подавляющем большинстве случаев аномалии коронарных артерий обнаруживаются посмертно, не являясь причиной смерти, или случайно при инструментальном исследовании по другому поводу и в течение жизни не вызывают патологических состояний. Таким образом, существуют предпосылки для определения новых «нормальных» вариантов анатомии коронарных сосудов, на что указывает P. Angelini в своих работах, предлагая идентифицировать коронарные сосуды по особенностям их средних и дистальных сегментов или микрососудистого бассейна, а не места отхождения и хода проксимальных сегментов.
Подавляющее большинство аномалий коронарных артерий доброкачественны, но существует группа аномалий, чреватых постоянными или периодическими нарушениями кровоснабжения миокарда и тяжелыми последствиями ишемии без ранней диагностики и лечения. Часто их единственным проявлением становится внезапная сердечная смерть. К этой группе относится синдром Бланда-Уайта-Гарланда.
Аномальное отхождение левой коронарной артерии от легочной артерии (ALCAPA — anomalous origin of the left coronary artery from the pulmonary artery), или синдром Бланда-Уайта-Гарланда (СБУГ), относится к редким врожденным порокам сердца (1 на 300 тысяч новорожденных) и составляет 0,25 % от всех ВПС.
СБУГ относится к гемодинамически значимым («большим») аномалиям коронарных артерий (КА). В 5% случаев сопровождает другие ВПС: открытый артериальный проток, дефект межжелудочковой или межпредсердной перегородки, тетраду Фалло, коарктацию аорты. Без должного лечения прогноз неблагоприятный. Средний возраст появления угрожающих жизни состояний при СБУГ составляет 33 года, а внезапной сердечной смерти — 31 год. Женщины болеют чаще.
Анатомическое описание порока впервые дал в 1911 году русский патологоанатом А.И. Абрикосов, описавший вскрытие 5-месячного ребенка с аневризмой левого желудочка. Исчерпывающее описание синдрома впервые дали E. Bland, P. White и J. Garland, работавшие в Массачусетской больнице общего профиля, в 1933 году.
Они описали случай 3-месячного ребенка с прогрессирующими проблемами с кормлением, кардиомегалией, выявленной при рентгенографии грудной клетки, и ЭКГ-признаками поражения левого желудочка. На вскрытии было обнаружено, что левая коронарная артерия (ЛКА) отходила от легочной артерии (ЛА). Эффективное лечение этой патологии нашлось только в 1960 году, когда Sabiston et al. показали наличие ретроградного тока крови из ЛКА в ЛА. Лигирование аномальной ЛКА в месте отхождения от ЛА спасло жизнь больному ребенку.
Аномальное отхождение ЛКА от ЛА возникает в эмбриогенезе в результате нарушения разделения конотрункуса перегородкой на аорту и ЛА или сочетания персистирования эндокардиальных подушек в легочной артерии и их дефективной инволюции в аорте. Генетические предпосылки заболевания не изучены. Предполагают, что причиной могут служить мутации в генах CFTR (трансмембранный регулятор муковисцидоза), MEN1 (множественная эндокринная неоплазия типа 1) и PKP2 (плакофилин-2).
Клиническая картина СБУГ
Спектр клинических проявлений СБУГ многообразен. Различают инфантильный и взрослый типы заболевания.
Рисунок 1 | Классификация СБУГ. Источник: Peña E. et al. ALCAPA syndrome: not just a pediatric disease //Radiographics. – 2009
При инфантильном, или летальном, типе СБУГ (85–90 % случаев) симптомы манифестируют обычно на втором месяце жизни. Новорожденные выглядят здоровыми, поскольку относительно высокое сопротивление ЛА пока еще поддерживает антероградный ток крови по аномальной ЛКА, а фетальный гемоглобин обеспечивает миокард кислородом. На 1–2 месяце жизни ребенка сопротивление сосудистого русла легких падает в связи с закрытием артериального протока, что ведет к уменьшению антероградного тока крови и перфузии миокарда.
Классические симптомы (приступы беспокойства, плача, колик, одышки, бледность, цианоз, потливость, срыгивание, сложности с кормлением), описанные Bland et al. в 1933 г., позволяют заподозрить патологию коронарных артерий. Как правило, приступы беспокойства возникают после или во время кормления или плача, когда повышается потребность миокарда в кислороде, и длятся несколько минут. Между приступами ребенок выглядит здоровым. Больные дети отстают в физическом развитии.
При осмотре обнаруживается расширение сердечной тупости, сердечный горб, аускультативно нормальные тоны и отсутствие шумов либо выслуживаются шум митральной регургитации, ритм галопа, изредка, чаще на 2–3 году жизни, мягкий непрерывный шум в верхних отделах по левому краю грудины, напоминающий шум у больных с коронарной фистулой или открытым артериальным протоком, усиление II тона над ЛА при развитии легочной гипертензии, гепатомегалия. Со временем из-за недостаточного развития коллатералей развиваются инфаркты переднебоковой стенки ЛЖ, недостаточность митрального клапана и хроническая сердечная недостаточность.
В ряде случаев регургитация на МК может маскировать проявления основного порока, что может привести к диагностической ошибке и неадекватной хирургической тактике. При отсутствии хирургической коррекции в 90 % случаев смерть наступает в течение первого года жизни.
Если у больного доминирует правый тип кровоснабжения сердца и имеется сеть многочисленных хорошо развитых межсосудистых анастомозов в системе коронарных артерий, симптомы могут отсутствовать или проявляться незначительно, и заболевание переходит во взрослый тип (10–15 % случаев). Некоторые взрослые пациенты с СБУГ не испытывают недомогания, но значительно чаще аномалия проявляет себя одышкой, сердцебиением, обмороками, стенокардией, легочной гипертензией, кардиомиопатией, желудочковыми аритмиями и внезапной сердечной смертью. Симптомы не всегда связаны с физической активностью и могут внезапно возникать в покое, результаты функциональных проб часто ложноотрицательные, что затрудняет диагностику.
Из-за развития большого числа коллатералей происходит шунтирование крови из правой коронарной артерии (ПКА) в ЛКА и ЛА и наблюдается феномен обкрадывания. В отдельных случаях СБУГ не проявляется до более позднего возраста (старше 30 лет), что объясняется адаптацией не только к хронической ишемии участка миокарда, кровоснабжаемого ЛКА, но и к шунтированию крови. Предполагается, что адаптация происходит благодаря:
- обеспечению перфузии ЛЖ из ПКА по коллатералям между ПКА и ЛКА;
- уменьшению территории миокарда, зависящей от ЛКА, в результате доминирования ПКА;
- уменьшения шунтирования крови из артериального в венозное русло из-за появления со временем стеноза устья ЛКА;
- развития коллатералей бронхиальных артерий, обеспечивающих перфузию ишемизированного миокарда.
Однако обычно адаптации не обеспечивают достаточное кровоснабжение ЛЖ и развивается хроническая субэндокардиальная ишемия миокарда, увеличивающая риск возникновения злокачественных желудочковых аритмий. В 80–90 % случаев СБУГ наступает внезапная сердечная смерть. Изначально считалось, что причиной внезапной сердечной смерти является гипоплазия КА, изгиб или перегиб проксимального эктопического сегмента КА (отходящего по касательной от аорты), острый угол отхождения и щелевидная или заслончатая форма устья КА, ход артерии между аортой и легочной артерии, что приводит к сдавлению («ножницы»).
P. Angelini выделяет несколько механизмов стеноза КА:
• Коронарная гипоплазия
Интрамуральный инвагинированный сегмент проксимальной эктопической артерии меньше в окружности, чем более дистальные экстрамуральные сосуды. Автор предлагает в качестве ценного количественного параметра индекс гипоплазии (отношение длин окружностей интрамурального сегмента и более дистального на внутрисосудистом УЗИ). Врожденный ход артерии в медии аорты скорее приводит к ненормальному росту КА до и после рождения.
• Латеральная компрессия
На поперечном разрезе интрамуральный сегмент имеет овоидную, а не круглую форму. Латеральное сдавливание уменьшает площадь по сравнению с площадью сечения круглого на разрезе сосуда с той же длиной окружности. Латеральное сдавливание характеризуется коэффициентом асимметрии (отношение меньшего диаметра к большему при внутрисосудистом УЗИ). В систолу диаметр еще больше уменьшается.
Таким образом, заподозрить у пациента СБУГ можно при наличии необъяснимой кардиомегалии, митральной недостаточности или стойкого систолического шума над областью сердца.
Инструментальная диагностика СБУГ
Рисунок 2 | Предлагаемый диагностический протокол для взрослых пациентов с риском развития аномалий коронарных артерий. Источник: Angeline P. Coronary artery anomalies—current clinical issues //Tex Heart Inst J. – 2002
В 80–90 % диагноз СБУГ устанавливается на вскрытии. Наиболее актуальна скрининговая диагностика аномалий коронарных артерий для спортсменов и военнослужащих. Согласно данным Американского Национального регистра внезапной смерти среди спортсменов аномалии КА являются второй по частоте причиной внезапной сердечной смерти (17 %), уступая лишь гипертрофической кардиомиопатии. Сообщается, что функциональные пробы и радионуклидные методы часто не выявляют временную ишемию у спортсменов с аномалиями КА. От 55 % до 93 % пациентов, умерших от внезапной сердечной смерти, вызванной аномалиями КА, не имели ранее кардиологической симптоматики и менее 10 % из них обращались к кардиологу с симптомами, связанными с аномалией.
Прямым указанием на СБУГ служит визуализация ЛКА, отходящей от легочного ствола (чаще всего от его левой нижнелатеральной части сразу за клапаном ЛА). Далее ЛКА следует по межжелудочковой борозде и распадается на левую переднюю нисходящую и огибающую артерии. Косвенными признаками СБУГ являются извитость КА, расширенная ПКА, множественные расширенные коллатерали между ПКА и ЛКА, гипертрофия и дилатация ЛЖ, миксоматозная дегенерация и ишемическая дисфункция папиллярных мышц, гипокинез стенки ЛЖ, расширенные бронхиальные артерии.
Диагностической процедурой выбора для диагностики СБУГ является коронарография с инъекцией в корень аорты, однако из-за анатомических особенностей устья аномальной ЛКА не всегда удается визуализировать ее ход. Аортография используется для лучевой диагностики у детей младше одного года, коронарография – у детей старше 5 лет. Процедура чревата осложнениями, среди которых часто встречаются временные изменения на ЭКГ (11 %), временная брадикардия (2,5 %), сосудистые нарушения (11,6 %) и такие серьезные осложнения, как желудочковая фибрилляция (0,6 %).
Большинство диагнозов СБУГ основаны на данных эхокардиографии с цветовым допплеровским картированием. ЭхоКГ позволяет избежать осложнений коронарографии и оценить дисфункцию МК. Дополнительные исследования проводятся при невозможности установить точный диагноз на ЭхоКГ или для дифференциальной диагностики. Трансторакальная ЭхоКГ используется у детей в связи с наличием хорошего акустического окна (у взрослых более чувствительна чреспищеводная ЭхоКГ).
Рисунок 3 | 3-месячный мальчик с аномальным отхождением ЛКА от легочной артерии
На трансторакальной ЭхоКГ (А, В) видно нормальное отхождение ПКА (стрелка на А) и ЛКА (стрелка на В). С. Ко-сая КТ сердца визуализирует нормальное отхождение ПКА (наконечник), однако отсутствует соединение (стрелка) ЛКА с левым аортальным синусом. D. Объемная реконструкция КТ четко визуализирует аномальное отхождение ЛКА (черная стрелка) от легочного ствола (белая стрелка). Виден расширенный левый желудочек. Источник: Goo H. W. Coronary artery imaging in children //Korean journal of radiology. – 2015
МРТ сердца дает дополнительную информацию о направлении тока крови в ЛКА (кино-МРТ с последовательностью SSFP), состоянии клапанов, миокарда, местной сократимости, сопутствующих пороках, которая важна для предоперационной оценки и послеоперационного наблюдения за пациентами. При исследовании пациент не подвергается ионизирующему облучению, что важно в педиатрии. МРТ сердца используется для обнаружения субэндокардиальной ишемии и фиброза миокарда, который может стать субстратом для возникновения летальных аритмий, при этом получают изображения с усилением в отложенную фазу после инъекции гадолиния.
На ЭКГ-синхронизированной МСКТ-ангиографии лучше, чем на МРТ, визуализируется не только аномальная ЛКА, но и расширенная и извитая ПКА, множественные межкоронарные коллатеральные сосуды, расширенные бронхиальные артерии.
Радионуклидные методы визуализации сердца позволяют оценить перфузию миокарда и функциональное значение аномалии КА. К ним относятся нагрузочная сцинтиграфия с таллием, однопротонная эмиссионная компьютерная томография и позитронная эмиссионная томография. Однопротонная эмиссионная КТ (ОПЭКТ)-МРТ и позитронная эмиссионная томография (ПЭТ)-МРТ выявляют ишемию миокарда у асимптоматических пациентов и пациентов с симптомами. При гибридном КТ-коронарография/ОПЭКТ-МРТ исследовании удается обнаружить нарушения кровотока в кровоснабжаемых КА участках даже при отсутствии дефектов перфузии. На решение об оперативном вмешательстве радионуклидные методы в целом не влияют и не используются при обследовании большинства пациентов.
Нередко первым признаком СБУГ являются нарушения ритма, представляющие риск развития внезапной сердечной смерти. Тем не менее, ЭКГ-признаки гипертрофии и перегрузки левых отделов сердца отмечают у всех пациентов с СБУГ. Перспективными в диагностике ишемии миокарда ЛЖ у данной категории больных могут быть поверхностное ЭКГ-картирование и метод 12-канального холтеровского мониторирования, помогающий выявить транзиторные периоды ишемии миокарда, даже при отрицательных результатах других нагрузочных проб.
ЭКГ у младенцев с СБУГ обычно указывает на переднебоковой инфаркт ЛЖ, признаками которого являются аномальные зубцы Q и временные изменения интервала ST в отведениях I, aVL, V5 и V6. У 20–45 % пациентов отсутствуют аномалии зубца Q и на мысль о СБУГ может навести аномальный прирост зубца R в грудных отведениях.
Различают временные, связанные с текущим повреждением, и более длительные, связанные с исчезновением мышечной ткани, изменения на ЭКГ. Первыми признаками повреждения являются заостренные зубцы Т, свидетельствующие о локальной гиперкалиемии, которые исчезают через несколько часов и часто не обнаруживаются. Затем последовательно появляются изменения сегмента ST, элевация точки J с сегментом ST вогнутой формы и дальнейшая элевация точки J с выпучиванием сегмента ST.
Иногда наблюдается реципрокная депрессия сегмента ST в отведениях II, III, aVF и даже V1 и V2. Признаками исчезновения мышечной ткани являются появление зубца Q и уменьшение амплитуды зубца R в затронутых отведениях. В течение последующих двух недель сегмент ST становится изоэлектрическим, зубец Т — инвертированным и симметричным, уменьшается амплитуда зубца R, углубляется зубец Q. Единственными ЭКГ-признаками переднебокового инфаркта после окончания острой фазы являются аномальные зубцы Q и R.
Вышеперечисленные изменения неспецифичны и характерны для острого миокардита и дилатационной кардиомиопатии, однако одновременное наличие следующих четырех ЭКГ-признаков присуще только СБУГ и позволяет провести дифференциальную диагностику:
- зубец Q выше 0.3 мВ (3 мм);
- ширина зубца Q больше 30 мс;
- qR-комплекс по крайней мере в одном из отведений: I, aVL, V5 и V6. Отсутствие зубцов Q во всех нижних отведениях (II, III, aVF).
Рисунок 4 | ЭКГ женщины 72-х лет с ALCAPA. Источник: Fierens C. et al. A 72 year old woman with ALCAPA //Heart. – 2000. – Т. 83. – №. 1. – С. e2-e2
Рисунок 5 | ЭКГ ребенка 3-х месяцев с ALCAPA. Источник: Hoffman J. I. E. Electrocardiogram of anomalous left coronary artery from the pulmonary artery in infants //Pediatric cardiology. – 2013
Данные изменения встречаются в 55–80 % случаев СБУГ. Причины отсутствия аномальных зубцов Q недостаточно ясны, однако у взрослых пациентов оно ассоциировано больше с субэндокардиальным инфарктом, чем с трансмуральным; больше с нижним, чем с передним; больше с мелкоочаговым, чем крупноочаговым. Стоит отметить и новые, но пока не получившие широкого применения, методы диагностики, например внутрисосудистое УЗИ и измерение интракоронарного давления с определением ФРК.
Дифференциальную диагностику СБУГ проводят с миокардитом, болезнью Кавасаки, васкулитами (узелковым полиартериитом или артериитом Такаясу), склеродермией, синдромом Элерса-Данло, наследственной геморрагической телеангиэктазией, дилатационной кардиомиопатией, врожденной недостаточностью МК, стенозом и коарктацией аорты.
Лечение СБУГ
Синдром Бланда-Уайта-Гарланда является абсолютным показанием к хирургическому лечению.
Выживаемость спустя 20 лет после операции, проведенной в младенчестве, составляет 95 %. Скудные данные о хирургическом лечении взрослых пациентов, переживших внезапную сердечную смерть, также выглядят многообещающими, однако до сих пор не проведено рандомизированных контролируемых исследований для оценки долгосрочных результатов разных способов коррекции порока.
В 1960 г. Sabiston et al., сотрудники Johns Hopkins Hospital, описали лечение 2,5-месячного ребенка с СБУГ. У ребенка наблюдались трудности при кормлении, одышка и звуки хрюканья. Рентгенография грудной клетки выявила кардиомегалию, на ЭКГ были признаки свежего повреждения миокарда. Катетеризация сердца выявила дилатацию и дисфункцию ЛЖ, аномальная ЛКА не визуализировалась. После полного обследования было принято решение о хирургическом вмешательстве с целью реваскуляризации ЛЖ. В ходе операции был обнаружен инфаркт миокарда и аномальная ЛКА.
С целью определить направление кровотока по аномальной КА Sabiston et al. измерили систолическое давление в ЛА и ЛКА, которое составило 25 и 30 мм рт.ст. соответственно. При окклюзии аномального сосуда в месте отхождения от ЛА давление в нем возросло до 75 мм рт.ст., обеспечив ретроградный кровоток по коллатералям. Сатурация кислородом в ЛКА составляла 100 %, в ЛА — 76 %, что также свидетельствовало о наличии кровотока по коллатералям. Sabiston et al. рекомендовали наложение лигатуры на аномальную ЛКА как эффективный метод лечения патологии.
В последние десятилетия были предложены несколько способов хирургического лечения СБУГ. Простое наложение лигатуры на аномальную артерию в месте ее отхождения от ЛА, описанное Sabiston et al., при своей эффективности оказалось чревато серьезными ранними и поздними осложнениями по той причине, что после наложение лигатуры коронарное кровоснабжение сердца обеспечивается только ПКА и целиком зависит от степени развития коллатералей. В 1966 г. Cooley et al. сообщили о способе создания двухкоронарной системы кровоснабжения миокарда. Создав с помощью протеза из дакрона сообщение между аортой и ЛКА, они восстановили прямой антероградный кровоток в ЛКА. В последующие годы были предложены другие способы создания двухкоронарной системы — шунтирование подкожной веной, внутренней грудной артерией, левой подключичной артерией.
Доказанными осложнениями перечисленных методов хирургической коррекции являются реканализация аномальной КА, увеличение риска атеросклероза, тяжелая ишемическая митральная регургитация. Более современные методы не несут за собой такие риски.
Современный способ хирургической коррекции СБУГ основан на предложенной в 1974 г. Neches et al. прямой имплантации ЛКА в аорту. Устье аномальной ЛКА выделяется из ЛА вместе с небольшим лоскутом ЛА и подсоединяется к корню аорты с формированием двухкоронарной системы. Описанный способ является операцией выбора при СБУГ. Послеоперационная летальность составляет 0–16 % в зависимости от степени дооперационного повреждения миокарда. Главным осложнением может стать тяжелая кровопотеря из-за разрыва аномальной артерии при пересадке. У взрослых прямая имплантация ЛКА часто невозможна из-за ригидности ткани и большим расстоянием от устья ЛКА до аорты. В этих случаях предпочтительным является шунтирование аномальной ЛКА с использованием артериального и венозного трансплантата. При этом риск стеноза пересаженного сосуда выше при использовании венозного трансплантата. Трансплантат подкожной вены сохраняет проходимость в среднем на 80 % в течение 5–8 лет.
При наличии противопоказаний к прямой имплантации ЛКА в аорту с 1979 г. применяется операция Takeuchi. Она заключается в создании тоннеля внутри ЛА (аортопульмонарного окна), через который аорта сообщается с устьем аномальной ЛКА. Данный метод ассоциирован с высокой частотой надклапанного стеноза легочной артерии и обструкции тоннеля.
Пациентам с необратимым, несмотря на коррекцию с формированием двухкоронарной системы, повреждением миокарда показана трансплантация сердца. У пациентов с высоким риском возникновения желудочковых фибрилляций (пациенты с ишемической кардиомиопатией и низкой фракцией выброса) возможно использование имплантируемого кардиовертера-дефибриллятора.
Источники:
- Yamanaka O., Hobbs R. E. Coronary artery anomalies in 126,595 patients undergoing coronary arteriography //Catheterization and cardiovascular diagnosis. – 1990. – Т. 21. – №. 1. – С. 28-40.
- Angelini P. Coronary artery anomalies: an entity in search of an identity //Circulation. – 2007. – Т. 115. – №. 10. – С. 1296-1305.
- Angelini P. Coronary artery anomalies—current clinical issues //Tex Heart Inst J. – 2002. – Т. 29. – С. 271-278.
- Клинические рекомендации по ведению детей с врожденными пороками сердца / Под ред. Бокерия Л.А. — М.: НЦССХ им. А.Н. Бакулева; 2014. — 342 с.
- Peña E. et al. ALCAPA syndrome: not just a pediatric disease //Radiographics. – 2009. – Т. 29. – №. 2. – С. 553-565.
- Quah J. X. et al. The management of the older adult patient with anomalous left coronary artery from the pulmonary artery syndrome: a presentation of two cases and review of the literature //Congenital heart disease. – 2014. – Т. 9. – №. 6. – С. E185-E194.
- Alsara O. et al. Surviving sudden cardiac death secondary to anomalous left coronary artery from the pulmonary artery: a case report and literature review //Heart & Lung: The Journal of Acute and Critical Care. – 2014. – Т. 43. – №. 5. – С. 476-480.
- Cowles R. A., Berdon W. E. Bland-White-Garland syndrome of anomalous left coronary artery arising from the pulmonary artery (ALCAPA): a historical review //Pediatric radiology. – 2007. – Т. 37. – №. 9. – С. 890-895.
- Hoffman J. I. E. Electrocardiogram of anomalous left coronary artery from the pulmonary artery in infants //Pediatric cardiology. – 2013. – Т. 34. – №. 3. – С. 489-491.
- Hekim N. et al. Whole exome sequencing in a rare disease: A patient with anomalous left coronary artery from the pulmonary artery (Bland-White-Garland Syndrome) //Omics: a journal of integrative biology. – 2021. – Т. 20. – №. 5. – С. 325-327.
Причины появления
Основной провоцирующей причины, на фоне которой возникает патологическое состояние, нет. Большая часть медиков склоняется к тому, что заболевание развивается в утробный период.
По мере формирования всех органов и систем в теле ребенка образуются синусоидальные сообщения (капилляры), которые в определенный период должны закрываться. Если этого не происходит, развивается коронарно-легочная фистула. Кровеносные сосуды жизненно необходимы организму человека, они поддерживают нормальный кровоток всего тела.
Другой причиной формирования артериально-легочного свища являются различные пороки сердечно-сосудистой системы. Патологические состояния характеризуются образованием шунтов между коронарными сосудами и желудочками.
Провоцирующие факторы, повышающие риск появления коронарно-легочной фистулы:
| Название | Причины |
| Врожденная фистула |
|
| Приобретенная |
|
Коронарно-легочная фистула у ребенка возникает также по причине различных нарушений и сбоев в системе кровообращения (атрезия легочной артерии). Установить точный диагноз и подобрать максимально эффективное лечение поможет детский врач кардиолог.
Диагностика
Важно дифференцировать заболевание, поскольку многие патологические процессы сопровождаются схожими признаками. Диагностика коронарно-легочной фистулы предусматривает проведение осмотра пациента и инструментальное обследование.
| Название | Описание |
| Аускультация сердца | Прослушивание специалистом систоло-диастолического шума позволяет выявить отличительные его черты. При впадении свища в предсердия усиливается систолический шум, в желудочки – диастолический. Максимальность интенсивного шума зависит от места дренирования фистулы. |
| Фонокардиография | Метод диагностики, при помощи которого выявляют патологические свищи, их размеры и степень расширения отверстия. |
| Ультразвуковое исследование с доплерографией | Специалист просматривает сердце, оценивает его функционирование и выявляет нарушения, свищи (патологические шунты). На УЗИ врач также видит расширение пораженной коронарной артерии. |
| Электрокардиография | Диагностический метод, который позволяет зафиксировать специфические изменения в работе сердца при образовании фистул большого размера. |
| Коронарография | Исследование позволяет получить объемное трехмерное изображение коронарных сосудов и образование патологической фистулы. |
| Мультиспиральная компьютерная томография (МСКТ) | Максимально информативный метод обследования сердца, который позволяет просмотреть орган в трех проекциях. То же самое касается и кровеносных сосудов. |
Коронарно-легочная фистула у ребенка
В ходе осмотра максимум информации врач получает при помощи аускультации сердца. Свищи большого размера провоцируют появление патологических шумов в сердце, приглушаются его тона.
Коронарно-легочная фистула у ребенка диагностируется врачом педиатром вместе с кардиологом. Специалисты оценивают состояние пациента, опираясь на результаты комплексной диагностики, и подбирают максимально эффективные терапевтические методы.
Методы диагностики артериовенозной фистулы
Магнитно-резонансная томография
Над областью предполагаемой артериовенозной фистулы врач может услышать шум тока крови. Движение крови через АВ фистулу создает звуки близкие к шуму двигателя автомобиля.
Если врач услышит этот шум, то, Вам необходимо будет пройти дополнительные методы исследования, такие как:
- Ультразвуковое исследование
— это наиболее эффективный и распространенный метод выявления артериовенозных фистул верхних и нижних конечностей. В этом исследовании инструмент, названный трансдьюсер, прислоняют к коже. Трансдьюсер испускает высокочастотные звуковые волны, которые отражаются от красных кровяных клеток, что позволяет оценить скорость кровотока. - Компьютерная томография (КТ).
КТ позволяет увидеть, минует ли ток крови капилляры. Вам будет сделана инъекция контраста, это препарат, который виден на компьютерной томограмме. Затем сканнер КТ будет двигаться, чтобы сделать снимки предполагаемой пораженной артерии. После этого снимки будут отправлены на монитор компьютера, для оценки Вашим врачом. - Магнитно-резонансная ангиография (МРА).
МРА может быть использована, если Ваш врач предполагает наличие артериовенозной фистулы в артерии, находящейся глубоко под кожей. Это исследование позволяет рассмотреть мягкие ткани организма. МРА работает по такому же принципу, как и магнитно-резонансная томография (МРТ), но включает использование специального препарата (красителя), позволяющего создать изображения кровеносных сосудов. Во время МРА или МРТ вы лежите на столе внутри длинного аппарата, похожего на трубу, продуцирующего магнитное поле. Аппарат МРТ использует магнитное поле и радиоволны для создания изображений тканей вашего тела. Используя эти снимки врач сможет обнаружить артериовенозную фистулу.
Профилактика
Предупредить врожденные аномальные патологии невозможно.
Но есть полезные советы, которые снижают риск появления нарушений в период планирования беременности и вынашивания плода:
- Необходимо полностью исключить вредные привычки (спиртные напитки, наркотические вещества, табачные изделия).
- Важно не заниматься самостоятельным лечением любых заболевание. Схему и курс терапии подбирает врач, учитывая состояние пациента и установленный диагноз. Многие медицинские препараты оказывают негативное влияние на плод.
- В случае наследственной предрасположенности к появлению коронарно-легочной фистулы, женщине необходимо в профилактических целях посещать лечащего врача, проходить обследования.
- Необходимо придерживаться здорового образа жизни, правильно и рационально питаться, умеренно заниматься спортом.
Патологические шунты требуют своевременной терапии. Профилактические обследования помогут выявить изменения на ранней стадии. Людям, которые находятся в категории риска, рекомендуется избегать больших физических нагрузок.
Приобретенные сосудистые аномалии можно предупредить, если необходимое оперативное вмешательство и биопсию будет проводить квалифицированный врач хирург.
Методы лечения
Терапия коронарно-легочной фистулы у ребенка и взрослого в большинстве случаев осуществляется оперативным путем. Медикаментозное лечение помогает устранить клинические симптомы, которыми сопровождается заболевание и предупредить серьезные осложнения. С фистулами небольшого размера у пациента больше шансов на благоприятный прогноз.
Лекарственные препараты
Коронарно-легочная фистула у ребенка лечится медикаментозно, если патологические свищи диагностированы небольшого размера и на ранней стадии. Важно строго придерживаться врачебных назначений, поскольку многие препараты провоцируют побочные эффекты. Пациентам назначаются диуретики, бета-блокаторы и вазодилататоры.
Прочие методы
При коронарно-легочной фистуле, диаметры которой превышают 2 мм, основным лечением является оперативное вмешательство. Техника проведения операции зависит от размеров образовавшегося свища, места его нахождения и количества патологических шунтов. Перед операцией специалисты также учитывают индивидуальные особенности организма больного.
Основная цель оперативного вмешательства – это убрать коронарно-легочную фистулу, чтобы предупредить застойные явления. Патологические изменения провоцируют развитие сердечной недостаточности.
Хирургическое лечение коронарно-легочных фистул у ребенка и взрослого осуществляется следующими методами:
| Название | Описание |
| Транскатетерная окклюзия | Оперативное вмешательство проводится при диагностике простых коронарно-легочных свищей у детей без сопутствующих патологий сердца или пороков. Аномальные сосудистые отверстия закрывают обтуратами, специальными спиралями или съемными цилиндрами. |
| Хирургическая коррекция | Открытый вид оперативного вмешательства, который проводится в большинстве случаев при множественных патологических свищах с образованием аневризмы на крупных кровеносных сосудах. В ходе операции хирург полностью устраняет появившиеся аномальные свищи. |
Открытая операция показывает хорошие результаты, даже при наличии сопутствующих заболеваний сердечно-сосудистой системы. После хирургического лечения пациента ждет длительный реабилитационный период, во время которого важно строго придерживаться рекомендаций врача, чтобы благополучно восстановиться.
Хирургическое лечение в 2% случаев заканчивается летальным исходом. Согласно медицинской статистике 3,6% — это инфаркт миокарда, риск появления которого повышается после операции.
Многие пациенты также сталкиваются с серьезными осложнениями после хирургического вмешательства:
- нарушение целостности патологической фистулы;
- фибрилляция желудочков;
- образование тромба в области коронарной артерии;
- ишемическая болезнь сердца.
У взрослых пациентов последствия операции встречаются чаще по сравнению с детьми, но в ряде случаев это единственно актуальный метод лечения.
Эндоваскулярное закрытие парапротезной аортальной фистулы окклюдером SearCare PDA
- С.А. Абугов
- В.В. Раскин
- М.В. Пурецкий
- Фролова Ю.В.
- Г.В. Марданян
- Т.А. Буравихина
- Домбровская А.В.
- Дземешкевич Сергей Леонидович
Резюме
Паравальвулярная фистула после протезирования аортального клапана увеличивает смертность и может приводить к сердечной недостаточности, требующей лечения. Повторная операция все еще является методом выбора, однако она сопряжена с высоким риском развития осложнений. В последнее время альтернативой хирургическому лечению становится эндоваскулярное (чрескожное) закрытие парапротезной фистулы с помощью окклюдеров (или спиралей). Мы описываем эндоваскулярное закрытие парапротезной аортальной фистулы у 72-летней пациентки, подвергшейся протезированию аортального клапана биологическим протезом. Пациентке с высоким риском повторной операции в связи с сопутствующей патологией под контролем аортографии и черспищеводной ЭхоКГ выполнена эндоваскулярная имплантация окклюдера SearCare PDA 8×10 мм. Кратко- и среднесрочный результаты операции были хорошими, отмечено снижение степени аортальной регургитации с АР 3-4 до АР 1. Эндоваскулярное закрытие парапротезной фистулы с использованием окклюдеров является выполнимой, но технически сложной процедурой. Мы полагаем, что оценка риска и пользы реоперации и эндоваскулярного способа закрытия должна проводиться консилиумом с участием сердечно-сосудистых и эндоваскулярных хирургов.
Ключевые слова:протезирование аортального клапана, парапротезная фистула, эндоваскулярный окклюдер
Клин. и эксперимент. хир. Журн. им. акад. Б.В. Петровского. — 2013. — № 1. — С. 87-90.
Протезирование аортального клапана (ПАК) — самая распространенная операция у пациентов с клапанной патологией. Практические руководства рекомендуют использование биологических протезов у пациентов старше 65 лет [1]. С увеличением продолжительности жизни населения количество таких операций стремительно растет. Так, среди пациентов старше 70 лет число больных с биологическими клапанами сердца значительно возросло — с 87% в 2004-2005 гг. до 95% в 2008-2009 гг. [2]. С ростом числа операций увеличиваются и случаи дисфункций протезов вследствие клапанзависимых осложнений. Одно из основных осложнений после ПАК — парапротезная фистула, оказывающая значительное влияние на ранний клинический и отдаленный результат. Наличие парапротезной аортальной регургитации после ПАК ассоциируется с увеличением смертности пациентов [3, 4]. Несмотря на то что повторное открытое хирургическое вмешательство считается стандартом для лечения данного осложнения, оно часто связано с высоким риском развития осложнений и смертности. Альтернативой повторной операции может служить эндоваскулярный метод закрытия парапротезных фистул.
Клинический случай
Пациентка Н., 72 лет.
Предъявляла жалобы на одышку и давящую боль в грудной клетке при минимальных физических нагрузках, иногда в покое, в том числе и в ночные часы.
Анамнез: более 15 лет назад при выполнении ЭхоКГ впервые был выявлен аортальный стеноз. В дальнейшем выраженность стеноза прогрессировала, от неоднократно предлагавшихся оперативных вмешательств пациентка отказывалась. По данным ЭхоКГ от 2009 г. пиковый градиент давления (PGr) на аортальном клапане (АК) — 84 мм рт. ст., от 2011 г. — 100 мм рт. ст.
24.10.2012:
по данным ЭКГ — неполная блокада передней левой ветви пучка Гиса, гипертрофия миокарда левого желудочка;
по данным РГ грудной клетки — горизонтальное положение сердца, увеличение в объеме за счет левого желудочка. Кальциноз АК;
по данным ЭхоКГ — ФВ 65%, ТМЖП — 1,2 см, ТЗСЛЖ — 1,3 см. АК: створки изменены, отмечен выраженный кальциноз створок с переходом на аортальное фиброзное кольцо, основание передней митральной створки; PGr — 147/93 мм рт. ст. Аортальная недостаточность I степени;
по данным коронарной ангиографии — передняя нисходящая артерия, огибающая артерия, правая коронарная артерия — без гемодинамически значимых стенозов.
06.11.2012
— операция протезирования АК биологическим протезом SorinMitroflow No 19:
по данным интраоперационной чреспищеводной ЭхоКГ после операции на протезе АК Мitroflow 19: Vmax — 2,5 м/с, PGr — 20,0/11,6 мм рт. ст. При ЦДК: в области комиссуры правой коронарной (RC) и некоронарной (NC) створок определена парапротезная фистула диаметром 2-3 мм с регургитацией до I-II степени.
В постоперационном периоде
отмечено увеличение дисфункции протеза:
по данным контрольной чреспищеводной ЭхоКГ — протез АК: Vmax — 3,4 м/с, PGr — 45/24 мм рт. ст. При ЦДК: аортальная недостаточность III-IV степени. В проекции RC определена парапротезная фистула шириной 6,5 мм. Струя регургитации занимает практически весь ВОЛЖ и достигает уровня ниже головок папиллярных мышц.
С учетом весьма высокого риска повторной операции консилиумом в составе кардиохирургов, эндоваскулярных хирургов, кардиологов, анестезиологов-реаниматологов принято решение об эндоваскулярном закрытии парапротезной фистулы.
28.11.2013
— закрытие парапротезной фистулы системой SearCare PDA:
процедура
— под местной анестезией 0,5% раствором новокаина пунктирована и катетеризирова- на правая общая бедренная артерия. Установлен интродюсер.
Выполнена контрольная аортография, на ко- торой визуализируется аортальная парапротезная фистула с регургитацией III степени (рис. 1).
При чреспищеводной ЭхоКГ размер дефекта составил 6,5 мм. Диагностический катетер проведен через парапротезную фистулу (рис. 2).
Затем через систему доставки под контролем РГ и ЭхоКГ проведен и позиционирован окклюдер SearCare PDA размером 8×10 мм (рис. 3).
На контрольной чреспищеводной ЭхоКГ от- мечена хорошая фиксация окклюдера, аортальная недостаточность II степени. Диаметр резидуальной парапротезной фистулы — 3 мм. Центральная транспротезная регургитация VC — 5мм. Таким образом, получено уменьшение диаметра парапротезной фистулы в 2 раза.
При контрольных ЭхоКГ в постоперационном периоде отмечено уменьшение степени аортальной недостаточности. Перед выпиской пациентки по данным трансторакального ЭхоКГ — аортальная недостаточность I степени.
Пациентка наблюдается амбулаторно, в настоящее время одышка при обычных физических нагрузках не беспокоит.
Через 3 мес:
по данным контрольной ЭхоКГ — левый же- лудочек: ФВ — 62%, ТМЖП — 0,9 см, ТЗСЛЖ — 1,0 см. Локальная сократимость не нарушена.
Протез АК: Vmax — 3,3 м/с, PGr — 44/24 мм рт. ст. При ЦДК: аортальная недостаточность I степени.
Митральная недостаточность I степени. Трикуспидальная недостаточность I степени. Недостаточность клапана легочной артерии 0-I степени. Легочной гипертензии нет.
Обсуждение
В настоящий момент основной способ лечения больных с дисфункциями искусственных клапанов сердца — хирургическая коррекция. Однако, несмотря на достигнутые успехи в кардиохирургии, сохраняется высокий уровень летальности, который при парапротезных фистулах достигает, по данным разных авторов [5-10], более 10%. Альтернативой хирургической коррекции парапротезных фистул может служить эндоваскулярный метод.
Вместе с тем необходимо отметить, что эндоваскулярная коррекция парапротезных фистул из- учена не в полной мере. В настоящее время нет данных об отдаленных результатах метода. Проце- дура занимает много времени, технически сложна, требует слаженной работы рентгенохирургов и специалистов функциональной диагностики. Успешное позиционирование окклюдера достигается в 62-92% случаев [11]. В основном польза процедуры заключается в уменьшении площади фистулы, что у большинства пациентов приводит к снижению функционального класса сердечной недостаточности по NYHA на одну ступень. Нерешенным остается вопрос о площади резидуальной фистулы: закроется ли она с течением времени и каким будет ее влияние на гемолиз. Эндотелизация окклюдера может привести как к полному закрытию резидуального просвета фистулы (так в теории), так и к увеличению площади оставшегося просвета за счет радиальной силы устройства. В настоящее время эндоваскулярное закрытие парапротезной фистулы выполнимо и может быть методом выбора у пациентов высокого риска по- вторной операции [12-15]. В каждой ситуации необходим мультидисциплинарный подход (с участием кардиохирурга, эндоваскулярного хирурга, специалиста функциональной диагностики) с оценкой риска и пользы повторной операции, а также эндоваскулярного закрытия парапротезной фистулы.
Литература
1. Guidelines on the management of valvular heart disease (version 2012) // Eur. Heart J. — 2012. — Vol. 33. — P. 2451-2496.
2. Dunning J., Gao Н., Chambers J. et al. Aortic valve surgery: Marked increases in volume and signiflcant decreases in mechanical valve use — an analysis of 41,227 patients over 5 years from the Society for Cardiothoracic Surgery in Great Britain and Ireland National database // J. Thorac. Cardiovasc. Surg. — 2011. — Vol. 142 (4). — P. 776-782. e3
3. Tamburino C., Capodanno D., Ramondo A. et al. Incidence and predictors of early and late mortality after transcatheter aortic valve implantation in 663 patients with severe aortic stenosis // Circulation. — 2011. — Vol. 123. — P. 299-308.
4. Zahn R., Gerckens U., Grube E. et al. The German transcatheter aortic valve interventions: registry investigators. Transcatheter aortic valve implantation: first results from a multi-centre real-world registry // Eur. Heart J. — 2011. — Vol. 32. — P. 198-204.
5. Pansini S., Ottino G., Forsennati P.G. et al. Reoperations on heart valve prostheses: An analysis of operative risks and late results // Ann. Thorac. Surg. — 1990. — Vol. 50. — P. 590-596.
6. Cohn L.H., Aranki S.F., Rizzo R.J. et al. Decrease in operative risk of reoperative valve surgery // Ann. Thorac. Surg. — 1993. — Vol. 56. — P. 15-20.
7. Jones J.M., O’Kane H., Gladstone D.J. et al. Repeat heart valve surgery: Risk factors for operative mortality // J. Thorac. Cardiovasc. Surg. — 2001. — Vol. 122. — P. 913-918.
8. Lytle B.W., Cosgrove D.M., Taylor P.C. et al. Reoperations for valve surgery: Perioperative mortality and determinants of risk for 1,000 patients, 1958- 1984 // Ann. Thorac. Surg. — 1986. — Vol. 42. — P. 632-643.
9. Akins C.W., Buckley M.J., Daggett W.M. et al. Risk of reoperative valve replacement for failed mitral and aortic bioprostheses // Ann. Thorac. Surg. — 1998. — Vol. 65. — P. 1545-1551.
10. Tyers G.F., Jamieson W.R., Munro A.I. et al. Reoperation in biological and mechanical valve populations: Fate of the reoperative patient // Ann. Thorac. Surg. — 1995. — Vol. 60. — P. S464-S468.
11. Y. Shapira, R. Hirsch, R. Kornowskietal. Percutaneous closure of perivalvular leaks with Amplatzer occluders: feasibility, safety, and short term results // J. Heart Valve Dis. — 2007. — Vol. 16(3). — P. 305-313.
12. Pate G.E., Al Zubaidi A., Chandavimol M. et al. Percutaneous closure of prosthetic paravalvularleaks: case series and review // Catheter Cardiovasc. Interv. — 2006. — Vol. 68 (4). — P. 528-533.
13. Webb J.G., Pate G.E., Munt B.I. Percutaneous closure of an aorticprosthetic paravalvular leak with an Amplatzer duct occluder // Catheter Cardiovasc. Interv. — 2005. — Vol. 65(1). — P. 69-72.
14. Sorajja P., Cabalka A.K., Hagler D.J. et al. Successful percutaneous repair of perivalvular prosthetic regurgitation // Catheter Cardiovasc. Interv. — 2007. — Vol. 70(6). — P. 815-823.
15. Dussaillant G.R., Romero L., Ramirez A., Sepulveda L. Successful percutaneous closure of parapros- thetic aorto-right ventricular leak using the Amplatzer duct occluder // Catheter Cardiovasc. Interv. — 2006. — Vol. 67 (6). — P. 976-980
Возможные осложнения
Отсутствие своевременной комплексной диагностики и правильно подобранной терапии приведет к серьезным последствиям. Пациентам важно быть под наблюдением врача кардиолога, особенно если они в группе риска.
Коронарно-легочная фистула у ребенка или взрослого провоцирует следующие осложнения:
| Название | Описание |
| Коронарная аневризма | Патологическое состояние, которое характеризуется выпячиванием стенки кровеносного сосуда. Основная причина – это ее истончение или растяжение. Без своевременного лечения повышается риск разрыва кровеносного сосуда, что приведет к смерти человека. |
| Хроническая ишемия миокарда | Происходит функциональное и органическое поражение тканей сердца. В большинстве случаев патологическое состояние является следствием хронического нарушения кровообращения. |
| Застойная сердечная недостаточность | Патологическое состояние возникает на фоне хронической перегрузки сердца. |
| Атеросклероз коронарной артерии | Заболевание, которое развивается в результате коронарно-легочной фистулы в 20-30% случаев. |
| Инфаркт миокарда | Патологическое состояние, при котором образуется очаг ишемического некроза в области сердечной мышцы. Причиной является острое нарушение коронарного кровообращения. |
Маленькие свищи могут быть не опасными, однако отсутствие правильно подобранной терапии приведет к их увеличению, на фоне чего появятся возможные последствия. Патологические свищи большого размера, которые не диагностировали своевременно, провоцируют смертельный исход.
Коронарно-легочная фистула представляет собой редко встречающееся патологическое состояние. В категории риска не только ребенок, но и взрослые люди. Нельзя игнорировать нарушения в работе сердечно-сосудистой системы. Необходимо сразу посетить терапевта или кардиолога, пройти комплексное обследование и начать лечение.
Виды артериовенозных свищей, их симптомы
Артериовенозные свищи (фистулы) бывают врожденные и приобретенные.
Врожденные артериовенозные свищи могут располагаться в любой части тела и нередко бывают связаны с локализацией невусов – родимых пятен, меланом и т.п.
Формируясь ещё на стадии внутриутробного развития человеческого эмбриона, врожденные артериовенозные свищи (фистулы) могут уже в первые недели и месяцы после рождения провоцировать патологическую ишемию (недостаточность кровоснабжения) конечностей и венозную гипертензию (синдром повышенного венозного давления). Это может сопровождаться пигментацией кожи, увеличением конечностей, гипергидрозом, набуханием подкожных вен и другими симптомами.
Появление приобретенных артериовенозных свищей (фистул) может стать следствием травм, ранений, а также последствием медицинских манипуляций – например, шунтирования. Также во время хирургических операций для осуществления гемодиализа артериовенозные свищи (фистулы) могут создаваться специально, для обеспечения эффективности данного лечения. Поэтому важно оперироваться у опытных квалифицированных врачей, обладающих современными техническими возможностями.
Появление больших артериовенозных свищей (фистул) сопровождается отеками и покраснением тканей, однако маленькие свищи (фистулы) могут себя никак не проявлять до момента появления сердечной недостаточности.